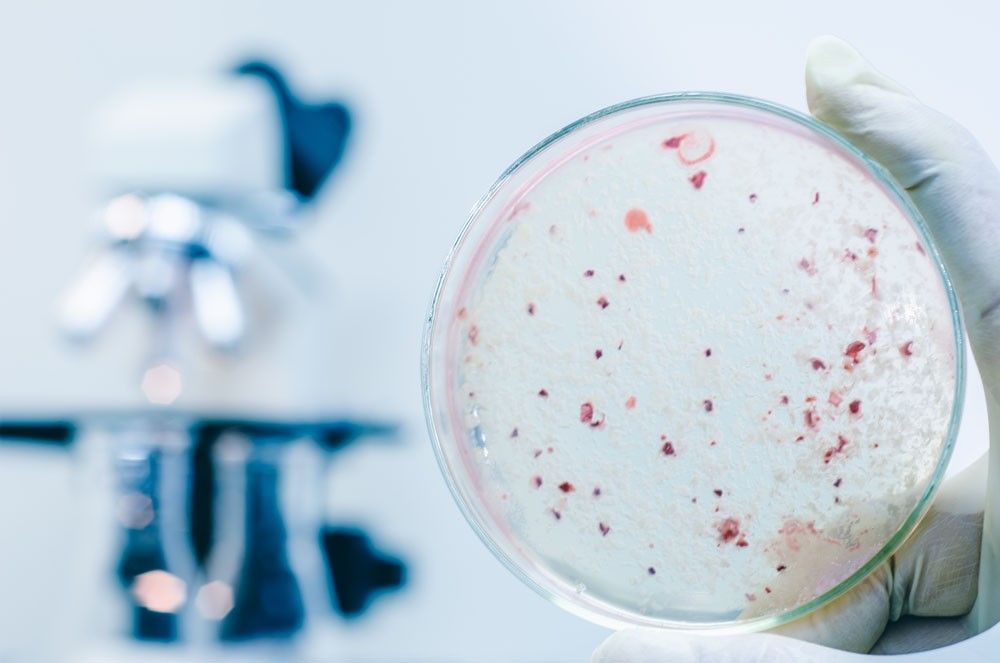
拆开洗衣机又脏又臭?教你一妙招,只需一泡,就把垃圾清空了

拆开洗衣机又脏又臭?教你一妙招,只需一泡,就把垃圾清空了
自从家里有了洗衣机,大家衣物清洁效率高了不止一倍
它为我们清洁衣物,但你有没有想过其实它也需要“洗澡”呢?

大家思考一下,洗衣机洗完衣服的脏东西,真的全都随着下水管流走了?

其实并没有!我们日常看到家里的洗衣机都是这样锃亮这样光洁如新的

感觉什么脏衣服放进去搅一搅,拿出来都会焕然一新,但实际情况跟你想象的完全相反!
但等你把自家洗衣机拆开后,你会发现内筒竟然这么脏!完全就是“脏衣机”!
其实洗衣机在清洗的过程中,衣物的毛屑、灰尘和污垢会从洗衣机槽的内壁孔眼进入到洗衣机槽内的外壁间隙,并附着在上面。
久而久之槽内就会堆积出一层又黑又黏的污垢,并滋生大量细菌。
上海市疾控中心抽样检查了使用半年以上的洗衣机,结果显示:霉菌检出率60.2%,细菌检出率81.3%,总大肠菌群高达100%。
注水30分钟后霉菌最高达4566个/升水,全自动洗衣机霉菌数是双缸的2.6倍,而滚筒洗衣机是波轮式的2倍。
央视《是真的吗》栏目中,也曾对洗衣机里藏有大量霉菌做过一次调查。
节目中,总院皮肤科主任医师杨维玲说,这些霉菌会引发皮肤过敏性疾病,脚癣、手癣甚至霉菌性阴道炎、慢性*麻疹荨**等。


这样的洗衣机,甚至比你家的马桶和下水道还要脏100倍!
而且洗衣机长时间不清洗,衣服等于白洗了;洗衣机内的霉菌、总大肠杆菌、绿脓杆菌是肉眼看不见的,但看不见不等于干净!

相信很多人跟小编一样,家里的洗衣机甚至两三年都没有洗过,也根本不知道洗衣机竟然还需要清洗。

那怎么清洗洗衣机呢?总不能我们每次也把洗衣机拆了之后慢慢刷吧!费时费力不说,拆坏了就彻底不能用了;
请专业人员上门?费时费力就算了又费钱!

而为了家人健康,小编也寻找了很多清洗洗衣机的办法。
最后经过对比,选择了一款高效的洗衣机专用清洗剂——而我们这期安利的好物,就是采用这一种安全天然的清洗方式,不用我们动手,洗衣机用它泡一泡,就会干干净净!
RENEWLL洗衣机清洁块

推荐理由
1、洗衣机祛除污垢干净如新
2、抑菌除螨99%,除臭留香
3、温和安全没刺激不伤机身
4、适合所有机型
1、治愈不干净,回归纯净先来夸夸这件可人爱的好物,包装里藏着一个白色的甜甜圈。

我们拿到手,第一次用只要丢2块进去,翻滚浸泡过的洗衣机,就是装了森林!清新好闻~

这种清洗方式,不用费力动手,就超干净~
只要加60°温水浸泡3小时,会排出污水干净如新。

光说没用,我们看看这个祛污实测
我家里用了2年的洗衣机,内筒看着很“干净”,但打开就有股霉臭味,好难闻。丢片清洁块进去,无数泡沫“滋滋”蹦跶着打扫内壁、清洁污垢。

等它泡上3小时再去看时,你会惊讶以为很干净的洗衣机,超脏的!飘浮一层层脏东西!

看着这些污垢,我感觉身上隐隐发痒
排出来的脏水,简直就是给洗衣机洗了一遍胃。

连桶壁的各个孔洞也变干净了,再洗衣服一点脏东西也没了,感觉就像刚买的一样。

而且还有一股清新气息在内筒蔓延,让每一件衣服能被更温柔的对待。

2、 吃掉那些脏污,守护健康
扒一扒成分,溶解吐出脏污的是活氧酵素和表面活性剂、祛污渗透剂。清洁效果是普通清洁剂的5倍,祛污力100%,轻松溶解祛除机身各种顽渍。

遇水打开污垢溶解通道,释放亿万个活氧泡沫,渗透内筒每个孔洞。

完全不用自己动手刷,就有像无数双隐形小手松动,搓洗运走所有脏污再冲入下水道。

平时家里用的洗衣机,不仅有大量污垢,还是个隐藏病毒体,能直接杀人于无形!没了健康,老人会整日痛苦,没了健康,孩子就不再欢笑,没了健康,孕妈身体岌岌可危。

这款清洁块有添加茶多酚、季胺盐杀菌剂、植物有机酸。吸收捕捉击杀病毒真菌率99.97%,对引病的大肠杆菌和沙门氏菌、金黄色葡萄球菌有强大抑制效果。

让我们在洗衣服后,防止病菌二次接触污染,避免过敏瘙痒。
还是医药食品级杀菌,对皮肤无刺激,孕妇宝宝都能放心用,更不用担心伤害机身哦,温和度真的没谁啦~

3、 3000万家庭,守护健康的共同选择
作为洗衣机清洁工,从用户99%的好评和97.8%的复购率来说,不少家庭已经把它当做必备品。
@ 而我很勇敢呐:
租的房子配了老旧洗衣机,每次衣服都有毛屑,那天只是随便用用,没想到漂了垃圾,吓人!清理掉后,才感觉安心了。

@ 巴诺木塔:
“以前身上总是发痒起红疙瘩,痒的睡不着,整个人被折腾的很疲惫。后来用了清洁块泡了几次洗衣机,瘙痒竟然没有找上门了!!!”

@琪琪MOM:
“女儿身体弱经常起红疹,现在每个月都会用清洁块泡衣机,不会担心病菌侵害了,宝宝身体也更健康了。”

虽然你还没有感受到清洁块的好,但相信我!
只要你拿到手,每次只用0.3元,就能看到洗衣机被泡出许多垃圾的舒畅感,拥有健康身体你会离不开它

每次挑选好物,我们会先了解品牌背景,这次也不例外。RENEWLL到现在有了5个年头,品牌一直在坚持着:“更好的生活品质,不等于昂贵的价格。

看到最后,你会发现我们有带来粉丝团购优惠:
一整包有15个清洁块,每2个月清洁一次洗衣机,已经能用上整整一年了!
你还在等什么,快点进来看看吧☟☟☟
【特惠15袋49】洗衣机槽清洁块芳香型 1块/袋
¥49
购买